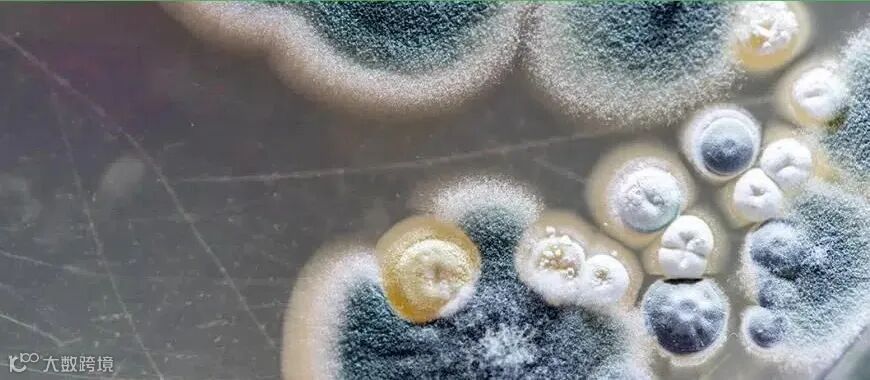

你知道真菌学吗?真菌学是一门专注于研究真菌的科学,包括真菌的遗传和生化特性及其对人类的影响。
真菌可以形成许多结构,包括霉菌。霉菌是可在不同环境中(空气、土壤、植物、动物和人类)发现的微小真菌。它们与高湿度有关。
霉菌将孢子分散在环境空气中,释放毒素或微生物挥发性有机化合物(MVOC)。虽然并非所有类型的霉菌都会导致疾病,但对一些人来说,吸入这些颗粒物会导致各种呼吸道症状(流鼻涕、气喘、咳嗽、头痛等),包括有毒霉菌综合征和霉菌引起的超敏反应。
为了预防潜在的感染,定期监测环境中的空气质量非常重要。Bertin Technologies设计生产的Coriolis空气采样器快速可靠,专门为提高室内或室外空气质量监测系统效率而开发。Coriolis与PCR和二代测序技术兼容,十多年来一直被用于研究生物气溶胶中的真菌生物量。
欢迎扫码填表索取应用资料
推荐阅读
>>在无人机上使用Coriolis空气采样器
>>使用Coriolis空气采样器研究废水处理中心病毒群落特征的宏基因组学方法
>>Coriolis:助力医院真菌感染监测
>>使用Coriolis空气采样器对空气中的病毒进行环境检测和监测
>>如何检测空气中的过敏源
>>【应用指南】利用Coriolis空气采样器检测空气中的细菌DNA
>>Coriolis µ空气采样器对医院SARS-CoV-2空气污染的评估
>>如何在医疗保健环境中实施空气传播病原体的监测
>>VirNext研究所利用Coriolis监测空气净化系统阻隔SARS-CoV-2的效果
>>Coriolis:挑战病毒检测
>>讲座视频回放:使用Coriolis空气采样器检测并监测SARS-CoV-2和气传病毒的理想方案
>>Coriolis Compact有效监控乳品厂的噬菌体浓度!
>>使用Coriolis空气采样器优化检测病毒、细菌和真菌的Top 3研究文章
>>Coriolis μ空气采样器:医院环境空气中SARS-CoV-2病毒的采集检测方案
>>Coriolis Compact:一种有效评估净化方法功效的工具
>>Coriolis:空气中过敏原、悬浮真菌孢子和病毒的收集与检测
>>Coriolis Compact空气采样器:气传细菌收集计数
>>Coriolis μ空气采样器:助力植物垃圾分类中真菌的检测
>>Coriolis Compact全新气旋式空气采样器视频介绍
>>Coriolis空气采样器可用于许多不同类型的室内和室外环境采样
>>Coriolis空气采样器,检测和监控医院、农场和工业场所的气传病毒
>>福利分享:Coriolis空气采样器在生产区控制污染物的存在
>>云DEMO:Coriolis Compact空气采样器-体形小巧, 续航力强
>>云DEMO:Coriolis空气采样器,新冠病毒收集利器
>>新款CORIOLIS COMPACT:空气污染监测的最佳合作伙伴
>>Coriolis µ空气采样器:助力NASA“探索计划”火箭升空前空气污染物的监测
>>Coriolis μ空气采样器:助力伦敦医院环境空气中SARS-CoV-2病毒的检测
>>MINI TALKS:环境中SARS-CoV-2病毒检测方案分享
>>Coriolis空气采样器助力SARS-CoV-2病毒RNA检测
>>Coriolis空气采样器助力亚欧多国新冠病毒收集和风险评估
>>MINI TALKS:如何进行空气中病毒的采样检测>>Coriolis空气采集器:助力医院环境中气传病毒的检测
>>Coriolis μ空气采集器:助力植物垃圾分类中真菌的检测
>>Coriolis μ空气采集器:助力面包厂中谷蛋白的检测
>>新品推荐:bertin Coriolis μ 空气生物采样器
>>法国Bertin Coriolis登陆极地,协助监控极地空气微生物及微颗粒
>>使用法国Coriolis µ改善空气微生物颗粒收集:从花粉到病毒
欢迎关注伯齐官方微信(微信公众号:Bio-Gene)
回复:Coriolis,查看更多相关视频
长按/扫描以下二维码可识别关注公众号

伯齐科技有限公司
Bio-Gene Technology Ltd.
广州伯齐生物科技有限公司
热线:176 2009 3784
www.bio-gene.com.cn
marketing@bio-gene.com.cn

